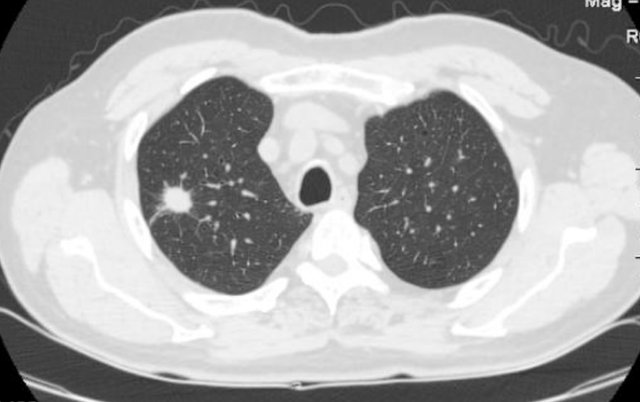
身体健康|晚上睡觉出现3种现象，或是肺部结节症状，为了身体健康也要了解

身体健康|晚上睡觉出现3种现象,或是肺部结节症状,为了身体健康也要了解
导语: 根据近几年的相关数据表明,我国在肺部疾病发病率越来越高,之所以会导致这种现象发生,原因非常的多,其中的空气污染是会受到影响的,再就是平常经常吸烟喝酒导致的不良习惯,容易损伤肺泡或者刺激肺部引起一系列的肺部疾病,比如肺结节就是常见的一种。

文章插图
什么是肺部结节?
其中的孤立性肺结节是比较常见的一种,它主要是指单一、边界清楚、影像不透明、直径小于或等于3cm、周围为含气肺组织所包绕的肺部结节病变,无肺不张、肺门增大或胸腔积液的表现。
孤立性肺结节为常见病,常见原因为肿瘤、感染性肉芽肿、先天性病变等原因,良性结节无症状可不进行治疗,恶性结节主要治疗方法为手术切除或放化疗,良性结节预后良好,恶性结节预后稍差。
文章插图
肺结节多由感染性因素所致,包括细菌感染、结核菌感染以及真菌感染,具体情况如下:
1、结核杆菌感染:表现为肺部结节,为临床常见病因;
2、隐球菌感染:与职业有关,如饲养鸽子、从事与土壤有关的工作,易引起肺部结节;
3、真菌感染:曲霉菌感染易引起结节。

文章插图
晚上睡觉出现3种现象,或是肺部结节症状,为了身体健康也要了解
第一种:睡觉时爱出汗
【 身体健康|晚上睡觉出现3种现象,或是肺部结节症状,为了身体健康也要了解】如果肺部出现一定的症状时,可能会影响肺气的运行,导致肺脏虚弱,如果你在凌晨三点左右出现睡眠不稳定,而且容易出汗的症状,一定要提高警惕,因为这个时候正是费比较活跃的时期,如果出现肺内有结节,就会影响到肺经正常活跃。
而且是经常出现这种症状,严重影响了睡眠质量,一定要去医院尽早检查,早治疗早康复。

文章插图
第二种:咳嗽时会带痰
患有肺病的患者大多数都是会经常咳嗽,然而经常出现时有痰,很多人认为是感冒症状,还有可能是另一种情况肺部出现肺结节,因为不同于感冒发烧的咳嗽带痰,由肺结节引起的咳嗽带痰并不能排除病菌,也不能像感冒发烧引起的咳嗽一样吃药治疗。
日常生活中不要认为这种现象只是简单的小感冒,如果经常出现这种症状,一定要去医院进行检查。

文章插图
第三种:胸闷气短
晚上睡觉的时候,如果经常出现胸闷气短的症状,并且感觉喘不上气来,并且呼吸困难,这很有可能肺部出现结节症状,进而扩散到了人的呼吸系统。
这个时候也不能过于忽视,建议早去医院进行检查,才有利于身体健康发展。

文章插图
想要消散结节,坚持做4件事,或对你有帮助
1、改善饮食习惯
很多时候饮食习惯与疾病的发生有着直接关系,想要消散肺结节,日常生活中一定在饮食上多加改变,比如平常爱吃的油炸食品以及腌制食品还有高糖食品都需要忌口。
建议平时以清淡为主,可以多吃一些银耳,它是一种可以润肺止咳的食物,银耳可以用来熬汤并且搭配两个枸杞,对身体的帮助非常有效果。

文章插图
2、适当运动
生命在于运动,日常生活的锻炼中可以帮助身体恢复健康,对于患有肺部疾病的朋友,适当的运动可以增强肺活量,由于减轻肺部的负担。
- 鸡蛋清性|每天晚上不妨多吃三种食物,营养丰富,延缓衰老,好吃又不贵!
- 肝胆疾病|女性晚上当零食吃几颗,美肤淡斑,大肚子也平了,越来越年轻
- 小林|男子一晚呼吸暂停176次?睡觉打鼾并非好事,背后或与这3件事有关
- 鼻息肉|全国有599万人睡眠中差点猝死?睡觉打呼噜,究竟要怎样才能改善
- 口臭|佩兰煎水喝治感冒便秘口臭,身体健康就是福。
- 便秘|苍耳子内服治鼻塞鼻炎,身体健康就是福。
- ▼每一个周日晚上|小南与你说晚安文|符志刚原文刊载于2022.|「小南夜读」腌冬菜
- 对话济南“路上咖啡”经营者:晚上营业的移动咖啡店|济南情侣路边售卖“茅台咖啡”,一杯48元,顾客“喝进去一口,什么都有”
- 感觉|体内血糖高,睡觉就能知?睡前若出现4个迹象,暗示你最好降血糖
- 苹果|早上金苹果,中午银苹果,晚上毒苹果?
